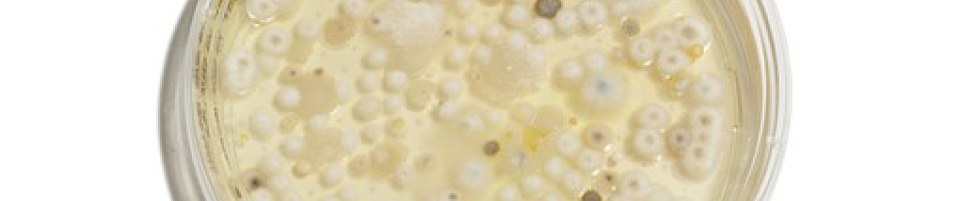

Schimmelpilze
Professionelle Schimmelbegutachtung in Oberbayern
Schimmelsporen finden sich überall...
... Unter bestimmten Bedingungen werden daraus Schimmelpilze. Neben falschen Nutzerverhalten sind häufig auch bauliche Mängel die Ursache für einen Schimmelbefall.
Auf jeden Fall besteht Handlungsbedarf!
Zertifizierte Spezialisten für Schimmelpilze:
Als zertifizierter Gutachter für Schimmel bieten wir:
- Beratung
- Inspektion mit Begehungsbericht
- Fachliche Stellungnahme
- Privatgutachten
Bei einem Schimmelbefall beraten wir Sie gerne. Schreiben sie uns an: